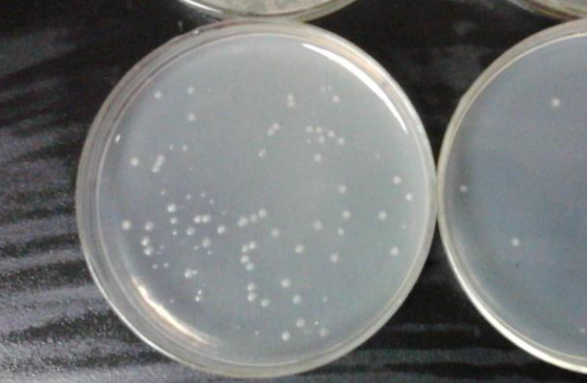

培养基放久了ph会改变吗
来源:网络收集 点击: 时间:2024-08-06【导读】:
会有所改变的。
培养液内的血清,生长因子等等在4度比较稳定,而室温放久了就会失效,pH也会有所变化。这里和培养液的成分,体积,储存条件等都有关。
培养基的使用原则,长期保存到20度,短期使用4度,每瓶打开使用应尽量在少数次数短时间内用完,所以要用合适的瓶子,所盛的培养基量在3到5次用完,4度长时间保存使用易污染,PH值易改变。
培养基分类及特点
培养基,是指供给微生物,植物或动物生长繁殖的,由不同营养物质组合配制而成的营养基质。一般都含有碳水化合物,含氮物质,无机盐包括微量元素,维生素和水等几大类物质。培养基既是提供细胞营养和促使细胞增殖的基础物质,也是细胞生长和繁殖的生存环境。
培养基种类很多,根据配制原料的来源可分为自然培养基,合成培养基,半合成培养基,根据物理状态可分为固体培养基,液体培养基,半固体培养基。根据培养功能可分为基础培养基,选择培养基,加富培养基,鉴别培养基等。
根据使用范围可分为细菌培养基,放线菌培养基,酵母菌培养基,真菌培养基等。培养基配成后一般需测试并调节pH,还须进行灭菌,通常有高温灭菌和过滤灭菌。培养基由于富含营养物质,易被污染或变质。配好后不宜久置,最好现配现用。
版权声明:
1、本文系转载,版权归原作者所有,旨在传递信息,不代表看本站的观点和立场。
2、本站仅提供信息发布平台,不承担相关法律责任。
3、若侵犯您的版权或隐私,请联系本站管理员删除。
4、文章链接:http://www.ff371.cn/art_1073065.html
上一篇:如何给狗狗做衣服
下一篇:手机如何让连接复印打印机#校园分享#
订阅